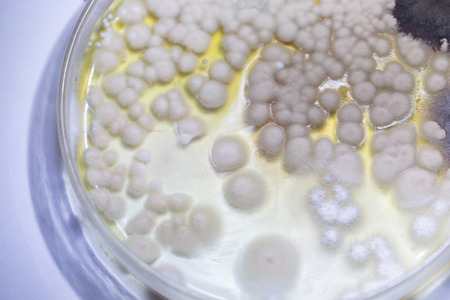
Colony characteristic of Actinomyces, Bacteria, yeast and Mold on selective media from soil samples for study in laboratory microbiology.の写真素材

写真素材 - Colony characteristic of Actinomyces, Bacteria, yeast and Mold on selective media from soil samples for study in laboratory microbiology.
作品情報
Colony characteristic of Actinomyces, Bacteria, yeast and Mold on selective media from soil samples for study in laboratory microbiology.
- ID:115675697
- 作品種別:写真
- 作者名:sinhyu
キーワード
- abstract
- actinomyces
- agar
- analysis
- background
- bacteria
- bacterial
- bacterium
- biology
- biotechnology
- characteristic
- colonies
- colony
- culture
- danger
- dirty
- disease
- dish
- education
- equipment
- experiment
- germs
- growing
- growth
- healthcare
- hygiene
- identification
- isolated
- lab
- laboratory
- media
- medical
- medium
- micro
- microbial
- microbiology
- mold
- organism
- pattern
- petri
- plate
- research
- sample
- science
- soil samples
- species
- test
- texture
- white
- yeast
類似作品
Close up petri ...
Aspergillus (mo...
The mesmerizing...
Close-up of a b...
An artistic dis...
This vivid view...
Air bubbles ins...
Microscopic vie...
a close-up port...
close-up of mic...
Abstract ink te...
Fungal colony u...
A sea of cilia ...
red glass textu...
3d rendered ill...
thousands of ti...
Close up petri ...
Abstract ink te...
Beautiful fract...
Mold microscopi...
Macro closeup o...
a close-up port...
close-up of bac...
Fluid abstract ...
microbiological...
Colony characte...
Vibrant Microbi...
close-up, micro...
pollen particle...
Backgrounds of ...
In the microsco...
Microscopic vie...
close-up of vib...
Colorful variet...
Backgrounds of ...
Mushroom cultiv...
An intricate vi...
Electron micros...
a close-up port...
A cobweb-shaped...
Smog art backgr...
Characteristics...
In the microsco...
A close up of m...
Colorful cells ...
Texture of natu...
Colony characte...
A petri dish te...
Macro shot of p...